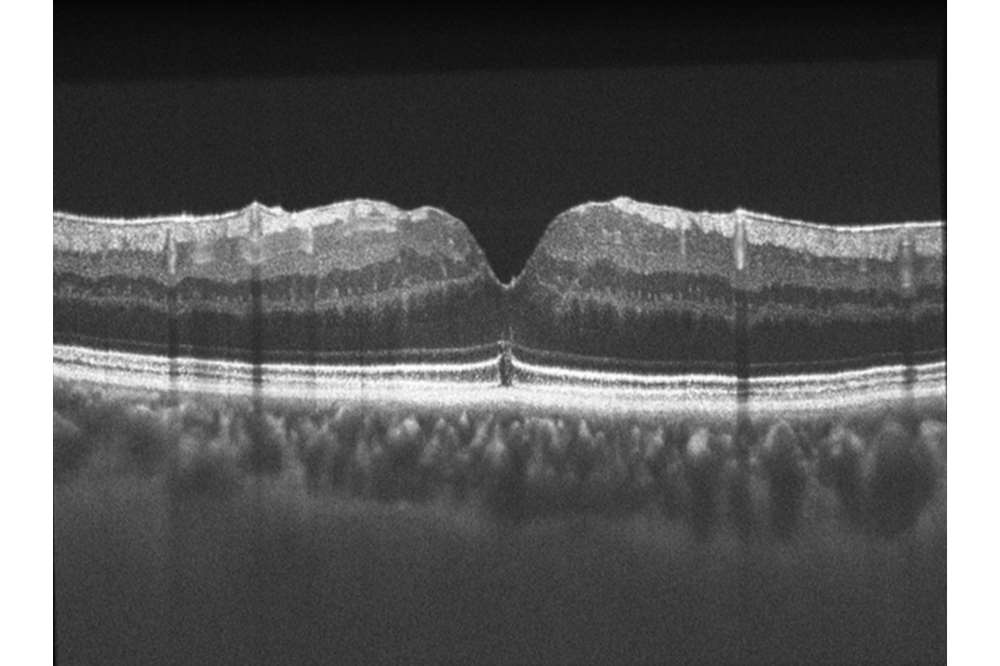

Retinal Images from the MCW AOIP
AOSLO Image Gallery
1 /

Achromatopsia Foveal Cone Mosaic
Shown is an image of the foveal cone mosaic acquired with split-detection AOSLO in a patient with congenital achromatopsia. Each circular structure is an individual cone photoreceptor inner segment.

Achromatopsia Peripheral Cone Mosaic
Adaptive optics confocal image (left), split-detector image (middle) and color merged image (right – confocal is displayed in orange, split-detector is shown in blue) of the photoreceptor mosaic in a patient with congenital achromatopsia at 2° from fixation. Scale bar 25 μm

Cone Mosaic Geometry
Image of the human cone mosaic, with the Voronoi domain of each cone superimposed. Voronoi analyses are used to characterize the packing geometry of the cone mosaic.

Cone and Rod Mosaic
Shown are time-averaged imaged from confocal AOSLO. The top images are of the cones at the center of the fovea, while the bottom images are of the peripheral retina (small cells are rods, larger cells are cones). The image on the right are log-transformed versions of the images on the right.

Peripheral Photoreceptor
Peripheral photoreceptor mosaic image generated by registering and averaging images taken over a span of 2 hours. The small cells are rods, larger cells are cones.

Retinitis Pigmentosa Foveal Cone
Magnified image of the normal appearance of the central foveal cone mosaic in a patient with retinitis pigmentosa (RP).

Best Disease
Shown is a montage of the foveal photoreceptor mosaic in a patient with Best disease, obtained with an adaptive optics scanning light ophthalmoscope. The large dark area aligns with a lesion seen on optical coherence tomography.

RPE Mosaic
The dark-field RPE imaging technique is able to resolve nearly all RPE cells in the fovea in some volunteers using near-infrared light.

Drusen
Multimodal imaging of an isolated druse. Top left is a magnified fundus autofluorescence image, top right is the corresponding photoreceptor mosaic seen with adaptive optics, bottom is an OCT B-scan of the same druse.

Retinal Blood Vessels
Fluorescein angiography image obtained using an adaptive optics scanning light ophthalmoscope, courtesy of Dr. Toco Chui and Dr. Richard Rosen, New York Eye & Ear Infirmary.

Variable Cone Mosaic Disruption in Red-Green Color Blindness
: Foveal AOSLO images for three subjects with red-green color vision deficiency caused by the LIAVA haplotype (and, for comparison, a normal control in the top left), illustrating the variability in photoreceptor mosaic disruption. Scale bar = 50 microns.

Disrupted Cone Mosaic in Red-Green Color Blindness
Image of the parafoveal photoreceptor mosaic in a patient with red-green color blindness due to a specific mutation in the L/M opsin genes (LIAVA).

The Split-Detector Advantage
Confocal AOSLO image (left) and corresponding AOSLO split-detector image (right) of the photoreceptor mosaic acquired at 10° of visual angle from fixation in a healthy volunteer. While sorting out rod versus cone structure is challenging using the confocal image, the cone inner segments are easily visualized using the split-detector modality. Scale bar 25 μm.

Cystoid Macular Edema in Retinitis Pigmentosa
The bubbled appearance of the top image (AOSLO montage of the photoreceptor mosaic) is caused by the presence of numerous cystic structures in the inner retina (seen in the lower OCT image).

13-Lined Ground Squirrel Cone Mosaic
This image shows photoreceptors from the cone-dominant 13-lined ground squirrel using confocal (left) and split-detection (right) AOSLO imaging (Scale bar = 20 μm)

13-Lined Ground Squirrel Optic Nerve
This is an image of the horizontal optic nerve head and nearby photoreceptors in a 13-lined ground squirrel.
OCT Image Gallery
1 /

Achromatopsia Fovea
This is an OCT image from a subject with congenital achromatopsia. Some photoreceptor disruption at the fovea is seen in this image and there is incomplete excavation of the inner retinal layers at the fovea.

Albinism Fovea
OCT image through the central retina of a patient with X-linked ocular albinism, illustrating the absence of a foveal pit (a.k.a., foveal hypoplasia)

Best Disease Fovea
OCT image through the fovea in a patient with Best disease, allowing visualization of the extent of the elevated lesion (which disrupts the appearance of the cone mosaic on AOSLO).

Choroideremia Outer Retinal Tubulation
Volume intensity projection (VIP) image from a patient with advanced choroideremia, with corresponding horizontal and vertical OCT B-scans. The circular structures in the B-scans are outer retinal tubules, and the VIP image reveals the interconnectedness of these structures.


Variation in Foveal Pit Morphology
OCT B-scans (left) and topographical thickness maps (right) showing the normal variability in the size and shape of the foveal pit.

OCT-A Image
OCT-A image, centered on the fovea, of a subject without ocular or systemic pathology.

OCT-A Image
OCT-A image centered on the fovea, of a subject with macular-foveal capillaries also known as a “fragmented” foveal avascular zone.
Postoperative Macular Hole
OCT B-scan from a patient 9 months following successful macular hole surgery.

Stargardt Disease
OCT – High-resolution Bioptigen OCT image from a patient with Stargardt disease.
Fundus Photography Image Gallery
1 /

Basal Laminar Drusen
Fluorescein angiography image of a patient with basal laminar drusen.

Best Disease
Color fundus image from a patient with Best disease, showing the classic “egg-yolk” lesion.

Choroideremia Carrier
Wide field autofluorescence image from a female carrier of choroidermemia obtained using the Optos imaging system.

Choroideremia Carrier
Fundus autofluorescence image from a female carrier of choroideremia obtained using the Spectralis imaging system.

Choroideremia
Color fundus image from a patient with choroideremia acquired using the Zeiss Visucam system.

Retinal Vasculature
Retinal vascular map obtained from the retinal function imager (RFI) from a healthy retina.

Ocular Albinism
Widefield color fundus image from a patient with ocular albinism obtained using the Optos imaging system.

Retinitis Pigmentosa
Wide field autofluorescence image from a patient with retinitis pigmentosa obtained using the Optos imaging system.

Retinitis Pigmentosa
Wide field fundus image from a patient with retinitis pigmentosa obtained using the Optos imaging system.

Stargardt Disease
Spectralis autofluorescence image from a patient with Stargardt disease.

Stargardt Disease
Spectralis autofluorescence image from a patient with Stargardt disease.